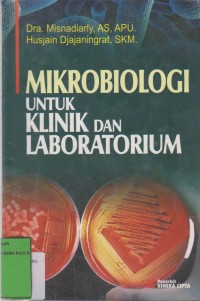
Image of Mikrobiologi untuk Klinik dan Laboratorium

Text
Mikrobiologi untuk Klinik dan Laboratorium
Buku ini membahas tentang Bakteri, Fungi, Parasit dan Virus untuk studi mengenal bakteri dan untuk keperluan peningkatan diagnosis yang cepat. Dibahas pula tentang morfologi kuman bakteri tertentu, jasad renik/kuman yang sering ditemukan pada berbagai organ penting manusia.
Ketersediaan
| AKJP1713S | 616.01 MIS M | My Library | Tersedia |
| AKJP1714S | 616.01 MIS M | My Library | Tersedia |
| AKJP1715S | 616.01 MIS M | My Library | Tersedia |
| AKJP1888S | 616.01 MIS M | My Library | Tersedia |
| AKJP1932S | 616.01 MIS M | My Library | Tersedia |
Informasi Detail
- Judul Seri
-
-
- No. Panggil
-
616.01 MIS M
- Penerbit
- Jakarta : Rineka Cipta., 2014
- Deskripsi Fisik
-
ix; 227 hlm; 23,5 cm
- Bahasa
-
Indonesia
- ISBN/ISSN
-
978-979-098-062-4
- Klasifikasi
-
616.01 MIS M
- Tipe Isi
-
text
- Tipe Media
-
-
- Tipe Pembawa
-
-
- Edisi
-
1
- Subjek
-
-
- Info Detail Spesifik
-
-
- Pernyataan Tanggungjawab
-
-
Versi lain/terkait
Tidak tersedia versi lain
Lampiran Berkas
Tidak Ada Data
Komentar
Anda harus masuk sebelum memberikan komentar
 Karya Umum
Karya Umum  Filsafat
Filsafat  Agama
Agama  Ilmu-ilmu Sosial
Ilmu-ilmu Sosial  Bahasa
Bahasa  Ilmu-ilmu Murni
Ilmu-ilmu Murni  Ilmu-ilmu Terapan
Ilmu-ilmu Terapan  Kesenian, Hiburan, dan Olahraga
Kesenian, Hiburan, dan Olahraga  Kesusastraan
Kesusastraan  Geografi dan Sejarah
Geografi dan Sejarah